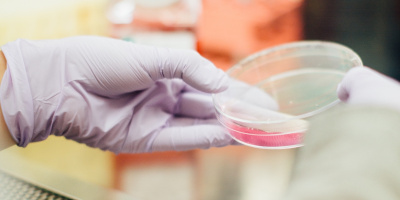

Воронежский государственный университет
5
1 отзывВоронеж
Государственный вуз

Статьи
 В Воронеже будет создан Турецкий образовательный центрОн также будет включать функции культурного центра.
В Воронеже будет создан Турецкий образовательный центрОн также будет включать функции культурного центра. В ВГУ пройдут открытые лекции по истории и химииПоследствия отмены крепостного права и уравнение Шредингера.
В ВГУ пройдут открытые лекции по истории и химииПоследствия отмены крепостного права и уравнение Шредингера. ВГУ будет готовить специалистов для фармацевтических предприятийОткрытие новой программы запланировано на 2018 год.
ВГУ будет готовить специалистов для фармацевтических предприятийОткрытие новой программы запланировано на 2018 год. Открыт набор на магистерскую программу «Русская литература в европейском контексте»Совместная программа ВГУ и Геттингенского университета.
Открыт набор на магистерскую программу «Русская литература в европейском контексте»Совместная программа ВГУ и Геттингенского университета. Открыт набор в летнюю школу по машинному обучениюКак научить искусственный интеллект отличать апельсины от яблок.
Открыт набор в летнюю школу по машинному обучениюКак научить искусственный интеллект отличать апельсины от яблок. ВГУ приглашает посетить «Субботний университет»Еженедельные открытые занятия для школьников и взрослых.
ВГУ приглашает посетить «Субботний университет»Еженедельные открытые занятия для школьников и взрослых. Как применить современные технологии в области медициныПридумают команды студентов, аспирантов и молодых ученых на «Medtech Hackaton».
Как применить современные технологии в области медициныПридумают команды студентов, аспирантов и молодых ученых на «Medtech Hackaton». Весной в ВГУ пройдет серия лекций о взаимодействии кино и литературыКурс подготовил филологический факультет к 100-летию университета.
Весной в ВГУ пройдет серия лекций о взаимодействии кино и литературыКурс подготовил филологический факультет к 100-летию университета.







